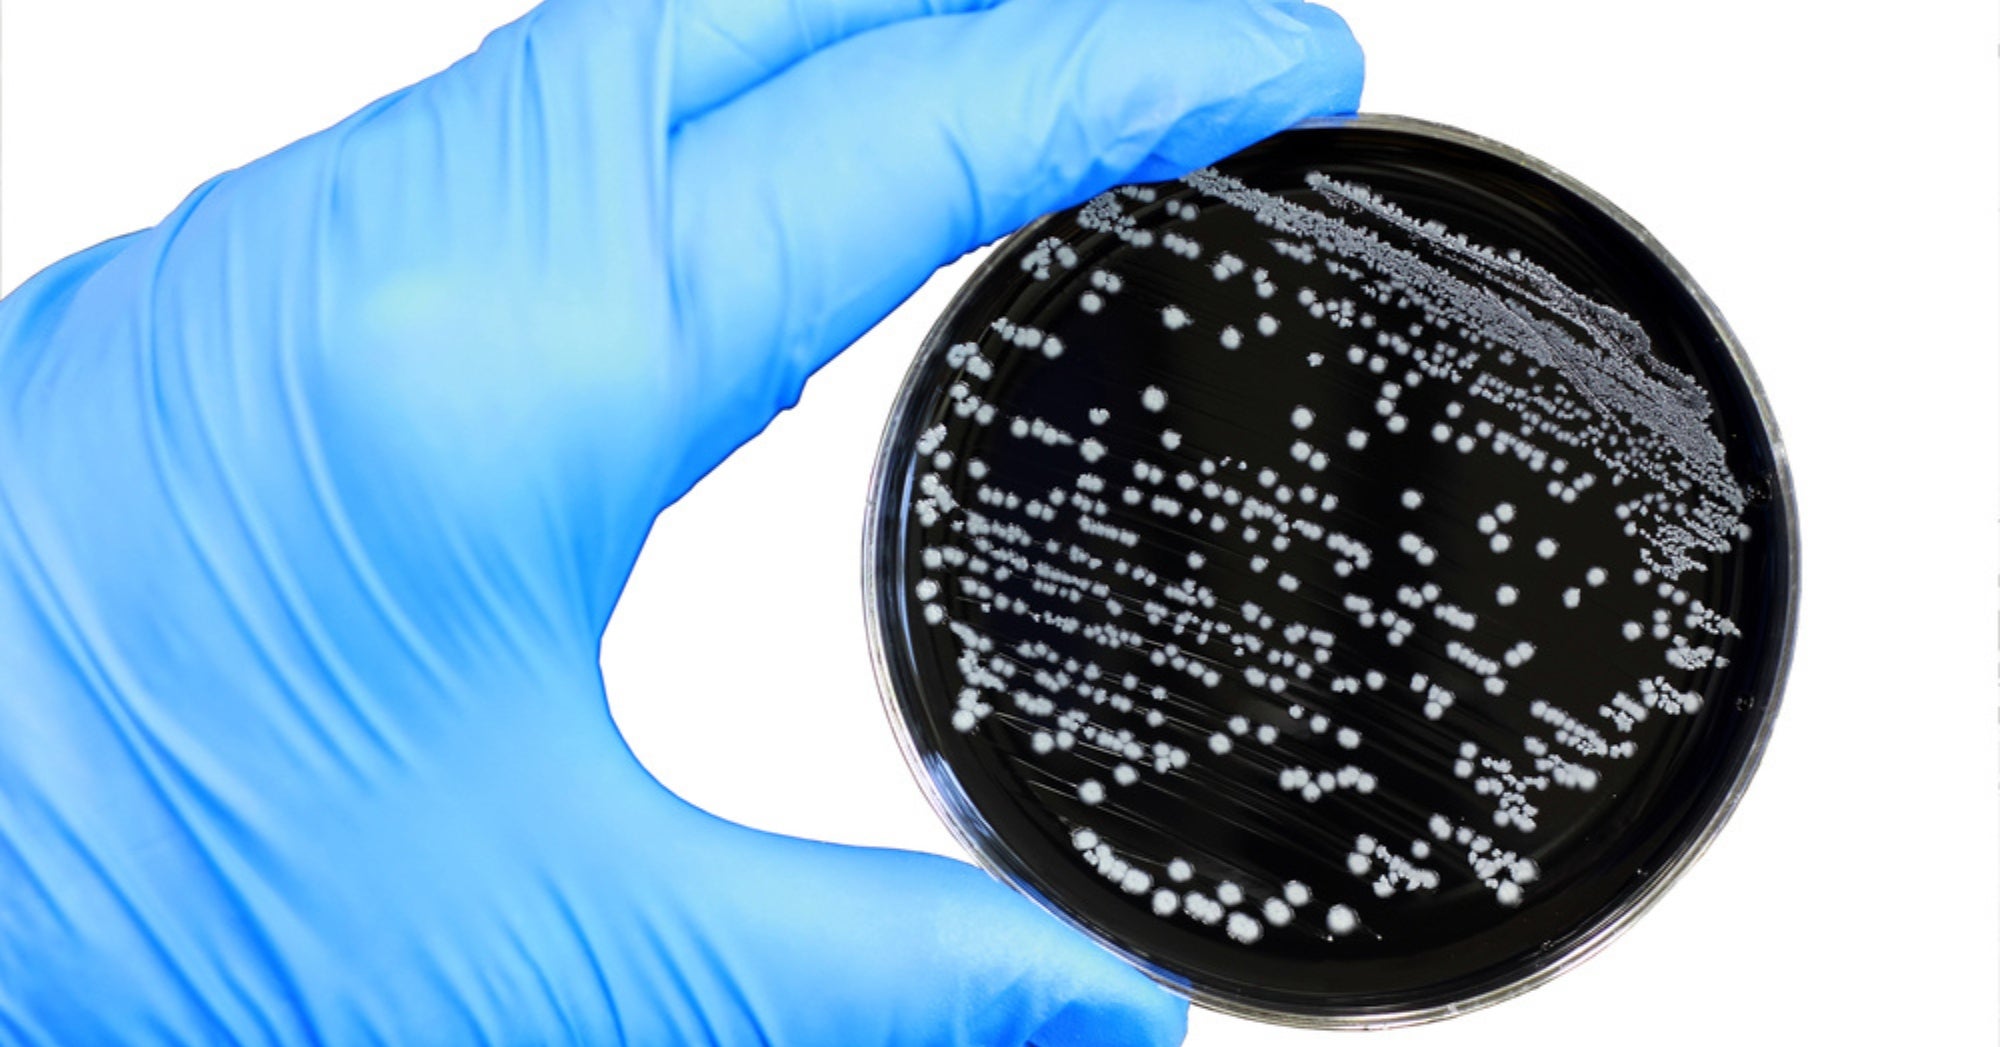
Campylobacter

Idaho state and local health officials are investigating a spike in illnesses reported after raw milk consumption, according to the Idaho Department of Health and Welfare.
Since Aug. 1, 2025, at least 23 cases of Campylobacter, including six children younger than 12, have been reported in Idaho among people who said they drank raw milk before becoming ill. The state DHW also reported three cases of Shiga toxin-producing E. coli, an infection that can cause especially serious complications in young children.
Cases have been reported across the state, with multiple people seeking medical care and two requiring hospitalization after consuming raw milk from various brands.
Symptoms associated with these infections can include vomiting, diarrhea, abdominal pain, fever, and dehydration. Complications can be severe, particularly for higher-risk groups such as young children, pregnant women, older adults, and people who are immunocompromised.
“People should be aware of possible health risks before consuming raw, unpasteurized dairy products or providing such products to family members, particularly people who might be at higher risk for illness, including young children, pregnant women, the elderly, and those who are immunocompromised,” the DHW wrote.
The DHW is encouraging anyone who recently consumed raw milk and is experiencing symptoms to seek medical care promptly. People can also contact their local public health district to report an illness or get additional information.
In Idaho, raw milk can be sold legally through multiple outlets, but it is not required to be tested for bacteria such as Campylobacter, E. coli, or other disease-causing agents.
Pasteurization is a widely used process in which milk is heated to a specific temperature for a set time to kill harmful bacteria in the milk.
Raw milk can contain harmful bacteria, including Campylobacter, E. coli, Listeria, and Salmonella, all of which are killed during the pasteurization process. In some cases, particularly among people in high-risk groups, complications can be severe.
»Related: Texas ag commissioner: Is raw milk worth the risk? We should get to decide









